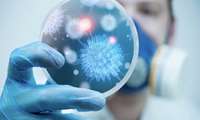
بزرگ‌ترین کشف ویروسی جهان با هوش مصنوعی انجام شد

آزمایش اولین واکسن جهان علیه ویروس تهوع زمستانی
در یک اقدام پیشگامانه، گروهی از پزشکان در انگلستان آزمایشات اولین واکسن جهان علیه «نوروویروس» یا «ویروس تهوع زمستانی» را آغاز کردهاند. این واکسن نویدبخش بهبود وضعیت سلامت عمومی و کاهش عوارض ناشی از این بیماری است.
یک ویروس، کلید کشف علت آلزایمر میشود
تحقیقات پیشرفته حاکی از این است که یک ویروس تاثیرگذار بر یک میلیون نفر آمریکایی در هر سال، میتواند ریسک ابتلا به زوال عقل را افزایش دهد.
سازمان جهانی بهداشت اعلام کرد:
اعلام فهرست 17 پاتوژن (عامل بیماری زا) اولویت دار برای توسعه فوری واکسن های جدید
سازمان جهانی بهداشت (WHO) اعلام کرد ۱۷ عامل بیماریزا را شناسایی کرده است که واکسنهای جدید برای آنها ضروری است زیرا اغلب باعث بیماری میشوند.
دسته جدیدی از پپتیدهای پروتِینی که دارای خواص ضد میکروبی قابل توجهی هستند کشف شدند
در یک پیشرفت قابل توجه در برابر تهدید فزاینده باکتری های مقاوم به آنتی بیوتیک، محققان دسته جدیدی از عوامل ضد میکروبی موسوم به پپتیدهای پنهان شده را شناسایی کرده اند.
ارتباط ویروسها با پارکینسون تایید شد
یک مطالعه نشان میدهد که عفونتهای ویروسی شدید، بهویژه انسفالیت و ذاتالریه، میتوانند خطر ابتلا به بیماریهای نورودژنراتیو مانند آلزایمر و پارکینسون را به طور قابل توجهی افزایش دهند.
هشدار سازمان جهانی بهداشت درباره شیوع یک بیماری کشنده جدید
به دنبال شناسایی ۲۷ بیمار مبتلا به ویروس بسیار مسری و کشنده ماربورگ (Marburg) در رواندا، سازمان جهانی بهداشت نسبت به خطر شیوع بالای این بیماری در سطح جهان هشدار داد.
بزرگترین کشف ویروسی جهان با هوش مصنوعی انجام شد
محققان با استفاده از هوش مصنوعی موفق به شناسایی بیش از ۱۶۱ هزار گونه جدید از ویروسهای RNA شدند. این کشف بهعنوان بزرگترین کشف گونههای ویروسی شناخته شده است.
تایید اولین واکسن افشانه ای برای جلوگیری از آنفلوآنزا
سازمان غذا و داروی آمریکا اولین واکسن به شکل افشانه (اسپری) بینی برای جلوگیری از دو گونه ویروس آنفلوانزا را برای افراد ۲ تا ۴۹ ساله تایید کرد.
اولین واکسن آبله میمونی برای استفاده جهانی تایید شد
سازمان جهانی بهداشت (WHO) اولین واکسن «امپاکس» (آبله میمونی) را برای استفاده جهانی تایید کرد.